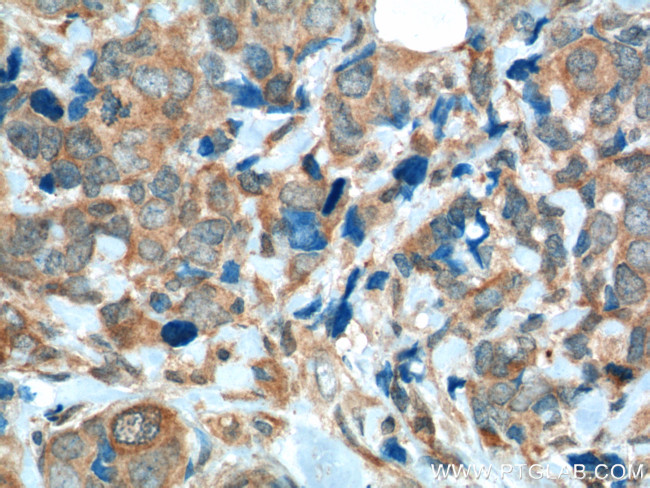
FGFR1 Antibody in Immunohistochemistry (Paraffin) (IHC (P))

Search
Proteintech
FGFR1 Monoclonal Antibody (10F12E7)
{{$productOrderCtrl.translations['antibody.pdp.commerceCard.promotion.promotions']}}
{{$productOrderCtrl.translations['antibody.pdp.commerceCard.promotion.viewpromo']}}
{{$productOrderCtrl.translations['antibody.pdp.commerceCard.promotion.promocode']}}: {{promo.promoCode}} {{promo.promoTitle}} {{promo.promoDescription}}. {{$productOrderCtrl.translations['antibody.pdp.commerceCard.promotion.learnmore']}}
产品信息
60325-1-IG
种属反应
已发表种属
宿主/亚型
分类
类型
克隆号
抗原
偶联物
形式
浓度
规格
纯化类型
保存液
内含物
保存条件
运输条件
产品详细信息
Immunogen sequence: LPRDRLVLG KPLGEGCFGQ VVLAEAIGLD KDKPNRVTKV AVKMLKSDAT EKDLSDLISE MEMMKMIGKH KNIINLLGAC TQDGPLYVIV EYASKGNLRE YLQARRPPGL EYCYNPSHNP EEQLSSKDLV SCAYQVARGM EYLASKKCIH RDLAARNVLV TEDNVMKIAD FGLARDIHHI DYYKKTTNGR LPVKWMAPEA LFDRIYTHQS DVWSFGVLLW EIFTLGGSPY PGVPVEELFK LLKEGHRMDK PSNCTNELYM MMRDCWHAVP SQRPTFKQLV EDLDRIVALT SNQEYLDLSM PLDQYSPSFP DTRSSTCSSG EDSVFSHEPL PEEPCLPRHP AQLANGGLKR R (471-821 aa encoded by BC018128)
靶标信息
FGFR1 (also known as FLT2) is a member of the Fibroblast Growth Factor Receptor family that constitute a family of four membrane-spanning tyrosine kinases (FGFR1-4) which serve as high-affinity receptors for 17 growth factors (FGF1-17). The FGF Receptor family plays an important role in multiple biological processes, including mesoderm induction and patterning, cell growth and migration, organ formation and bone growth. FGFR1 is alternatively spliced generating multiple splice variants that are differentially expressed during embryo development and in the adult body. Other defects in FGFR1 are responsible for several diseases which include Pfeiffer syndrome (PS), idiopathic hypogonadotropic hypogonadism (IHH), Kallmann syndrome type 2 (KAL2), osteoglophonic dysplasia (OGD), non-syndromic trigonocephaly, Jackson-Weiss syndrome, Antley-Bixler syndrome. Chromosomal aberrations involving this gene are associated with stem cell myeloproliferative disorder and stem cell leukemia lymphoma syndrome.
仅用于科研。不用于诊断过程。未经明确授权不得转售。
生物信息学
蛋白别名: 2.7.10.1; Basic fibroblast growth factor receptor 1; BFGFR; CD331; CD331 antigen; FGF Receptor; FGF receptor-1 precursor; FGFR; fgfr 1; FGFR-1; FGFR1/PLAG1 fusion; fibroblast growth factor receptor (FGFr) transmembrane form; Fibroblast growth factor receptor 1; fibroblast growth factor receptor FGFR-1 secreted form; FLT-2; FMS-like tyrosine kinase 2; fms-related tyrosine kinase 2; heparin-binding growth factor receptor; hydroxyaryl-protein kinase; N-sam; Proto-oncogene c-Fgr; unnamed protein product
基因别名: bFGF-R-1; BFGFR; CD331; CEK; ECCL; FGFBR; FGFR-1; FGFR1; FLG; FLT-2; FLT2; HBGFR; HH2; HRTFDS; KAL2; N-SAM; OGD
UniProt ID: (Human) P11362
Entrez Gene ID: (Human) 2260